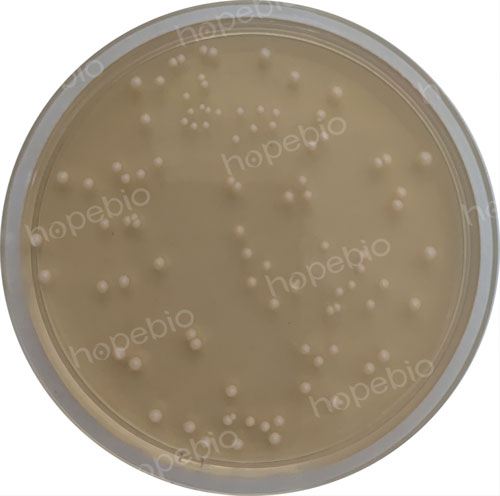
1%吐温80-玉米琼脂培养基微生物质控结果

海博微信公众号
海博微信公众号
 海博天猫旗舰店
海博天猫旗舰店


 海博微信公众号
海博微信公众号
 海博天猫旗舰店
海博天猫旗舰店




一、产品介绍
用途:用于鉴定白色念球菌和霉菌(产芽管试验)。
原理:玉米浸粉提供微生物生长所需的碳源和其他营养成分;琼脂是培养基的凝固剂。
二、培养基配方(g/L)
|
玉米浸粉 |
7.0 |
|
琼脂 |
15.0 |
三、试验方法
1、称取本品22.0g,另取吐温80 10.0g,加热溶解于1000mL蒸馏水中,混匀,分装,121℃高压灭菌15分钟,备用。
2、制备质控菌液接种于本培养基。
3、放置于23℃-28℃需氧培养24h-48h,观察试验结果。
四、质控结果
接种以下质控菌株,放置于23℃-28℃需氧培养24h-48h。结果如图1。
|
质控菌株 |
菌株编号 |
接种量(CFU) |
生长情况 |
其他特征 |
|
白色念珠菌 |
CMCC 98001 |
50-100 |
+++ |
白色菌落 |
图1 1%吐温80-玉米琼脂培养基微生物质控结果
芽管实验镜检结果如图2。

图2 芽管实验镜检图结果
相关产品:
注:本文属海博生物原创,未经允许不得转载。
上一篇:HC琼脂原理和使用方法



